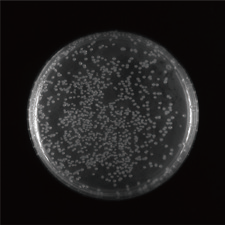
image015.png

-
生物通官微
陪你抓住生命科技
跳动的脉搏
全能成像,尽在掌握——Eagle Chemi多功能成像分析系统
【字体: 大 中 小 】 时间:2024年08月23日 来源:基因有限公司
编辑推荐:
Eagle Chemi多功能成像分析系统由基因集团最新自主研发,采用创新科技,具有高度集成、高性能、智能操作等特点,为科研实验提供高效、精准的成像解决方案。
Eagle Chemi多功能成像分析系统由基因集团最新自主研发,采用创新科技,具有高度集成、高性能、智能操作等特点,为科研实验提供高效、精准的成像解决方案。
作为一款全新推出的多功能成像分析系统,Eagle Chemi具备卓越的成像采集能力,集凝胶成像、化学发光、多色荧光成像于一体,覆盖大多分子生物学实验室中多样化的实验需求。
产品特点
01 集成化LED光源

三波段集成透射LED光源搭配双通道落射紫外光源、RGB荧光光源及双通道近红外荧光光源。
透射光源:紫外、蓝光、白光;
落射光源:紫外、白光、RGB荧光、双波长近红外荧光;
7位电动滤光轮,支持滤光片自动匹配光源。
多功能集成化设计,满足凝胶成像、化学发光成像、荧光成像需求。
02 高性能光学系统

采用高分辨率科研级相机,先进的制冷降噪和图像处理技术,可支持长达60min的长曝光;
高分辨率大光圈电动聚焦镜头,不同应用可获得精准对焦效果,提升成像质量。
03 模块化高度集成设计

一体机设计,15.6英寸大尺寸触摸屏;
不同应用模块可灵活配置;
可根据实验需求选配不同相机和镜头,为客户定制化设计。
04 智能化操作系统

支持自动曝光&对焦、一键采集;
样品板自动识别匹配光源;
创新设计可折叠切胶防护板,自动识别开启光源,智能切胶。
05 审计追踪

为企业客户提供了全面、准确、可溯源的实验数据支持。
06 应用范围

紫外凝胶成像

蓝光凝胶成像
菌落板成像

PAGE胶成像

Western Blot

Dot Blot成像

荧光成像

叶片发光成像
可用于核酸、蛋白、印迹膜、荧光成像等检测。
试用申请
